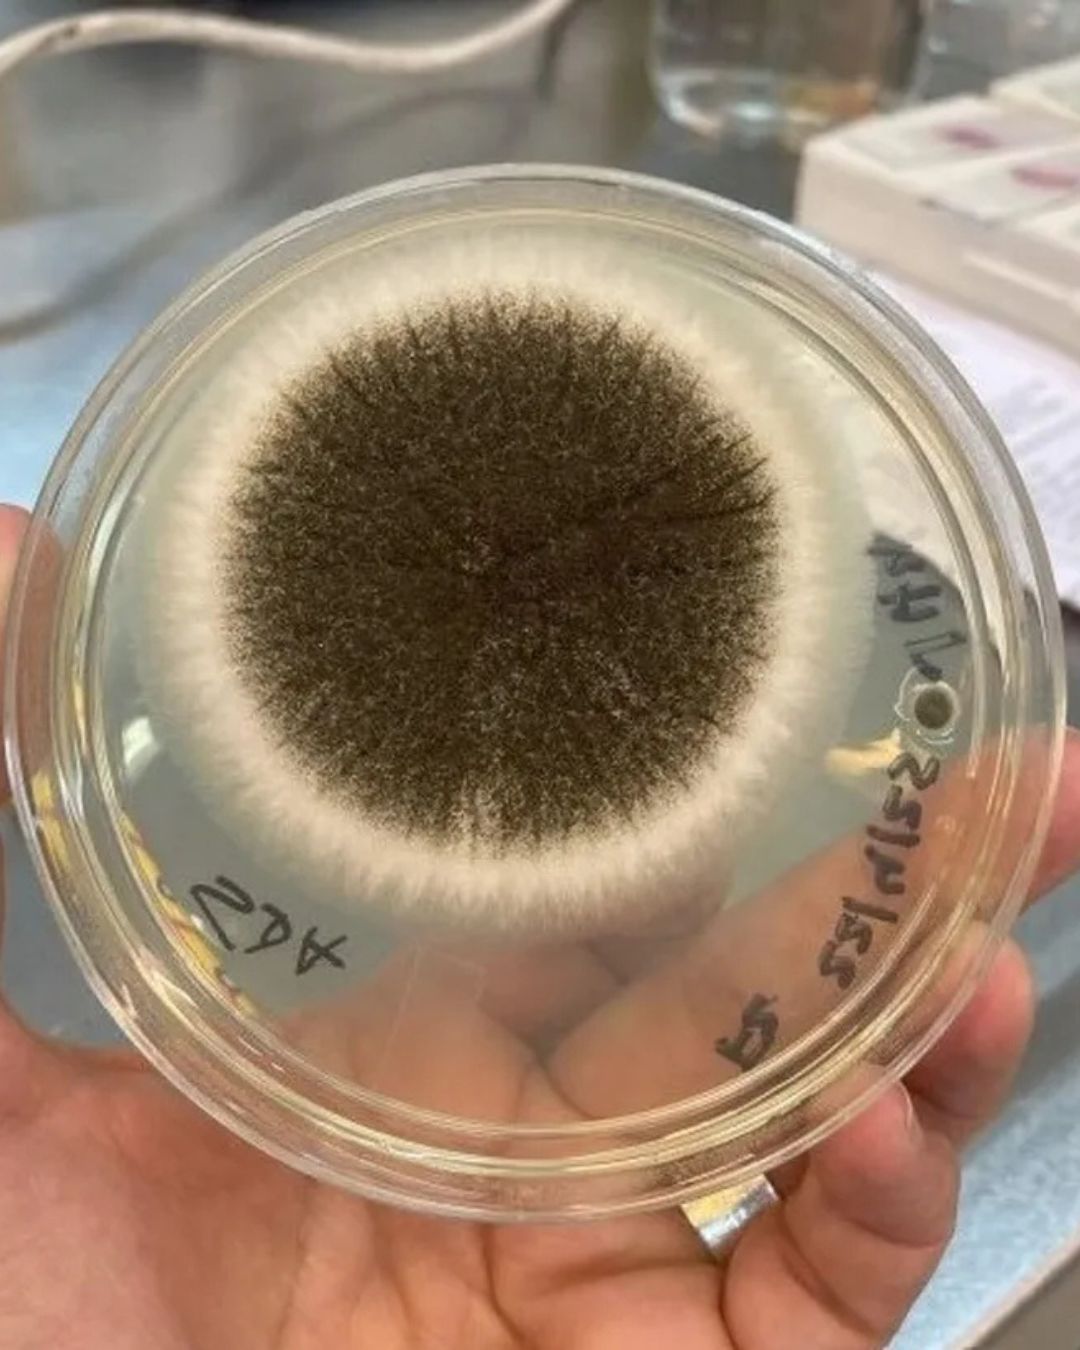
calidad aire escuelas ANEP

Analizan calidad del aire en escuelas de la ANEP: ven nexo entre concentración de dióxido de carbono y bacterias
Con el objetivo de cumplir con una propuesta que hizo el GACH en 2020, investigadores de diversas instituciones, financiados por la Universidad de la República, realizaron un estudio interdisciplinario inédito en la región.
Hay estudios y reglamentación precisa sobre el agua que bebemos, pero el aire no ha corrido la misma suerte. Se estima que las personan pasan el 90% de su vida en un ambiente cerrado, ya sea público o privado. Y la pandemia del Covid-19 dejó en evidencia lo importante que es ventilar los espacios cerrados, como los hogares, las oficinas y los salones de clase. “La calidad del aire implica procesos de generación y emisión de contaminantes —ya sea físicos, químicos, biológicos—, de transporte dentro del ambiente y potencial interacción con las personas, incluyendo su eventual inhalación si corresponde, y la ocurrencia de efectos inmediatos y de largo plazo sobre la salud”, explicó el núcleo interdisciplinario Calidad del Aire Interior. Este equipo de investigadores midió por dos años la calidad del aire dentro y fuera de escuelas públicas de Montevideo, un camino inédito en el país por su carácter interdisciplinario que dejó algunos hallazgos y virus y microorganismos congelados.
Hay estudios y reglamentación precisa sobre el agua que bebemos, pero el aire no ha corrido la misma suerte. Se estima que las personan pasan el 90% de su vida en un ambiente cerrado, ya sea público o privado. Y la pandemia del Covid-19 dejó en evidencia lo importante que es ventilar los espacios cerrados, como los hogares, las oficinas y los salones de clase. “La calidad del aire implica procesos de generación y emisión de contaminantes —ya sea físicos, químicos, biológicos—, de transporte dentro del ambiente y potencial interacción con las personas, incluyendo su eventual inhalación si corresponde, y la ocurrencia de efectos inmediatos y de largo plazo sobre la salud”, explicó el núcleo interdisciplinario Calidad del Aire Interior. Este equipo de investigadores midió por dos años la calidad del aire dentro y fuera de escuelas públicas de Montevideo, un camino inédito en el país por su carácter interdisciplinario que dejó algunos hallazgos y virus y microorganismos congelados.
En agosto de 2020, cinco meses después de que se detectaran los primeros casos de Covid-19 en Uruguay, el Grupo Asesor Científico Honorario (GACH) emitió un informe sobre “los mecanismos de transmisión” del virus. En el documento, firmado por el profesor e infectólogo uruguayo Julio Medina, se formularon “recomendaciones prácticas para operación y mantenimiento de sistemas de ventilación y calefacción en edificios para la reducción del riesgo durante la pandemia”, se recomendó realizar un “abordaje integral” del asunto y “estimular la creación de un grupo multidisciplinario que aborde y paute el control del aire en distintos ambientes”. Dos años después, en 2022, la Universidad de la República (Udelar) lanzó una convocatoria, en el marco de Espacio Interdisciplinario, y uno de los núcleos presentó como “objetivo general” cumplir con la propuesta de Medina y el GACH. Así se conformó un equipo que, desde 2023 hasta agosto de este año, midió desde diversos ángulos la calidad del aire de salones y del entorno de cuatro escuelas de Montevideo que funcionan en dos edificios, ambas con ventilación natural: puertas y ventanas.
Los investigadores midieron la concentración de dióxido de carbono (CO2), la temperatura y la humedad relativa del aire de forma permanente. Ingenieros electrónicos diseñaron los dispositivos de medición (“de muy bajo costo, que funcionan a pila”, destacó una de las investigadoras), para los que usaron sensores ya disponibles en el mercado. Fuera de las escuelas instalaron estaciones meteorológicas, que también registraron temperatura y humedad. Además, midieron, a través de encuestas, el confort térmico de las personas: si sentían frío o calor.
A su vez, los investigadores realizaron muestreos microbiológicos del aire, a partir de los cuales se estimó la concentración de bacterias y hongos. A partir de estos registros, en el futuro es posible determinar la presencia de virus e identificar las bacterias presentes gracias a las muestras congeladas. También midieron la concentración de material particulado (PM2,5 y PM10) dentro y fuera de los salones, así como dióxido de nitrógeno (NO2) dentro de las aulas.
El núcleo fue integrado por investigadores del área de la salud, la microbiología, la arquitectura y la ingeniería ambiental, mecánica y eléctrica, quienes trabajan en diversas instituciones: el Clemente Estable, Ceibal, el Instituto de Higiene y las facultades de Ingeniería, Arquitectura y Medicina.
“La calidad del aire y particularmente el nivel de ventilación de salones de escuela resultan de gran relevancia para la salud de niñas, niños y adultos que los habitan, potencialmente afectando además su desempeño escolar”, expresaron al presentar su proyecto. Dos años después, una de las investigadoras, Paola Scavone, licenciada en Bioquímica y doctora en Microbiología, del Clemente Estable, reveló uno de los hallazgos en diálogo con Búsqueda: a mayor CO2 registrado, más cantidad de bacterias, hongos y partículas. Por el contrario, en menor concentración de CO2, hubo menor recuento de bacterias, hongos y menor concentración de partículas. La primera recomendación es, otra vez, ventilar. De qué manera hacerlo fue uno de los dilemas estudiados.
Mirá la nota completa aquí



